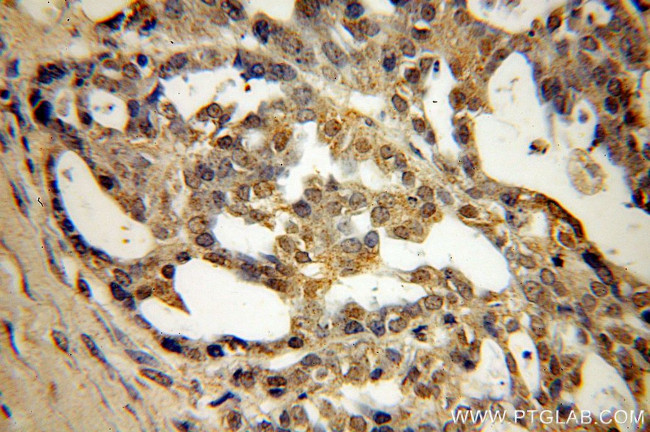
SPA17 Antibody in Immunohistochemistry (Paraffin) (IHC (P))
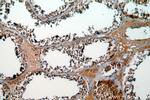
SPA17 Antibody in Immunohistochemistry (Paraffin) (IHC (P))

Search
Proteintech
SPA17 Polyclonal Antibody
{{$productOrderCtrl.translations['antibody.pdp.commerceCard.promotion.promotions']}}
{{$productOrderCtrl.translations['antibody.pdp.commerceCard.promotion.viewpromo']}}
{{$productOrderCtrl.translations['antibody.pdp.commerceCard.promotion.promocode']}}: {{promo.promoCode}} {{promo.promoTitle}} {{promo.promoDescription}}. {{$productOrderCtrl.translations['antibody.pdp.commerceCard.promotion.learnmore']}}
产品信息
13367-1-AP
种属反应
已发表种属
宿主/亚型
分类
类型
抗原
偶联物
形式
浓度
规格
纯化类型
保存液
内含物
保存条件
运输条件
产品详细信息
Immunogen sequence: MSIPFSNTH YRIPQGFGNL LEGLTREILR EQPDNIPAFA AAYFESLLEK REKTNFDPAE WGSKVEDRFY NNHAFEEQEP PEKSDPKQEE SQISGKEEET SVTILDSSEE DKEKEEVAAV KIQAAFRGHI AREEAKKMKT NSLQNEEKEE NK (1-151 aa encoded by BC032457)
靶标信息
This gene encodes a protein present at the cell surface. The N-terminus has sequence similarity to human cAMP-dependent protein kinase A (PKA) type II alpha regulatory subunit (RIIa) while the C-terminus has an IQ calmodulin-binding motif. The central portion of the protein has carbohydrate binding motifs and likely functions in cell-cell adhesion. The protein was initially characterized by its involvement in the binding of sperm to the zona pellucida of the oocyte. Recent studies indicate that it is also involved in additional cell-cell adhesion functions such as immune cell migration and metastasis. A retrotransposed pseudogene is present on chromosome 10q22.
仅用于科研。不用于诊断过程。未经明确授权不得转售。
生物信息学
蛋白别名: band 34; Cancer/testis antigen 22; CT22; Sp17; Sp17-1; Sperm autoantigenic protein 17; Sperm protein 17; Sperm surface protein Sp17; unnamed protein product
基因别名: CT22; SP17; SP17-1; SPA17
UniProt ID: (Human) Q15506, (Mouse) Q62252
Entrez Gene ID: (Human) 53340, (Mouse) 20686, (Rat) 85244